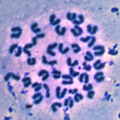

আরও সংক্ষিপ্ত
আপনার মতামত প্রদান করুন
কনটেন্টটি শেষ হাল-নাগাদ করা হয়েছে: মঙ্গলবার, ১০ এপ্রিল, ২০১৮ এ ০৮:২৭ AM
ফিশারিজ ল্যাব প্রকল্প
কন্টেন্ট: পাতা
| ফিশারিজ ল্যাব হোম | প্রকল্প | জনবল | প্রকাশনা | যোগাযোগ |
ফিশারিজ বায়োটেকনোলজি বিভাগের চলমান প্রকল্প
 | ১. ইলিশের বংশগত গঠন অনুসন্ধানের জন্য মাইক্রোস্যাটেলাইট মার্কার উদ্ভাবন অর্থায়নঃ ন্যাশনাল ইনস্টিটিউট অব বায়োটেকনোলজি বাস্তবায়নঃ ফিশারিজ বায়োটেকনোলজি বিভাগ প্রকল্পের মেয়াদঃ ২০১৩-২০১৬ [বিস্তারিত] |
| ২. ইলিশ মাছের ক্যারিওটাইপ নির্ণয় অর্থায়নঃ ন্যাশনাল ইনস্টিটিউট অব বায়োটেকনোলজি বাস্তবায়নঃ ফিশারিজ বায়োটেকনোলজি বিভাগ প্রকল্পের মেয়াদঃ ২০১৪-২০১৫ [বিস্তারিত] |
 | ৩. ক্রায়োপ্রিজারভেশন পদ্ধতির মাধ্যমে বিলুপ্তপ্রায় ভাঙ্গন মাছের জীন ব্যাংক তৈরি অর্থায়নঃ ন্যাশনাল ইনস্টিটিউট অব বায়োটেকনোলজি বাস্তবায়নঃ ফিশারিজ বায়োটেকনোলজি বিভাগ প্রকল্পের মেয়াদঃ ২০১৪-২০২০ [বিস্তারিত] |


